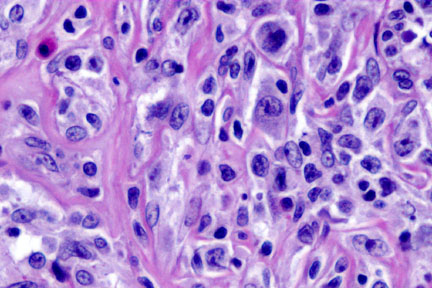

Go to:

TOC
|
Mediastinal (Thymic) Large B-Cell Lymphoma: Images

Strands of delicate fibrosis divide the lymphoma cells into compartments |
The lymphoma cells vary in size and shape. Many of them have ample cytoplasm, which in some cases appears clear. |
Table of Contents
|